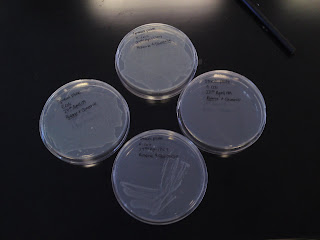

God grant me serenity to accept the things i cannot change,
the courage to change the things i can,and,
the wisdom to know the difference
In JESUS name,
AMEN
Soulmate lyrics
Incompatible, it don't matter though
'cos someone's bound to hear my cry
Speak out if you do
You're not easy to find
Is it possible Mr. Loveable
Is already in my life?
Right in front of me
Or maybe you're in disguise
Who doesn't long for someone to hold
Who knows how to love you without being told
Somebody tell me why I'm on my own
If there's a soulmate for everyone
Here we are again, circles never end
How do I find the perfect fit
There's enough for everyone
But I'm still waiting in line
Who doesn't long for someone to hold
Who knows how to love you without being told
Somebody tell me why I'm on my own
If there's a soulmate for everyone
If there's a soulmate for everyone
Most relationships seem so transitory
They're all good but not the permanent one
Who doesn't long for someone to hold
Who knows how to love you without being told
Somebody tell me why I'm on my own
If there's a soulmate for everyone
Who doesn't long for someone to hold
Who knows how to love you without being told
Somebody tell me why I'm on my own
If there's a soulmate for everyone
If there's a soulmate for everyone
slpt for like 4hours only -.-
before heading down to pioneer mrt
to meet up with the rest for the SFS competition
its been awhile since i saw everyone,
and yea i do i miss them =)
so the ppl in my team are
ivan,carlos,nana,sam,clement,clifford,johnny,andre,ee shan
dont think i missed out anyone.
but yea.
the competition was okay
but the seeding n order of it totally sucked.
anw my team got 4th automatically
and i duno why even though we only lost one game
to RJC -.-"
it was a freaking close score with 5-4
they scored in the last 10secs
damn.
screw the bloody seeding system
we didnt even get to fight for 2nd or 3rd placing -.-
but at least
i got to see david,kenneth,weekian,choon they all
its been so so so long since i saw them
roars!
meet up soon k guys! =)
roars, i swear
i duno if its me or what
but i realise, in wdv competition i join
i will nv get champs
i duno if im jinx or what luh =(
cause if i rmb correctly the first few proper competition i ever joined
was like when i was a toddler and i got 2nd n 3rd placing only
and since den..i dont think i won anything else in a proper competition
sigh.
its been so so so long since i receive an award or something =(
and yea
my confidence level is bloody low now
because of frisbee and my studies
both made me feel like a total loser
oh wells.
gtg back to doing my report now =/
i completely dont have a life now.
i swear my parents are getting freaking irritating.
i duno whats wrong with them luh seriously
they are like stricter now compared to when im sec school
like freaking hell!
like "GO TO BED NOW!I DONT CARE GO TO BED NOW!"
"PACK YOUR STUFF NOW!NOW!IF NOT YOU DONT LEAVE THE HOUSE!NOW!"
knn and i thought becoming older,
i'll have more freedom
looks like its the other way round!
argh.
and like what,
im being forced, i repeat FORCED to go to hongkong with them from the 7-9Aug
wtfreak luh.
i totally dont feel like going to hongkong luh
i hate going on a holiday esp when i started schooling alrdy
cause i'll freaking forget everything thing once i go on a holiday
roarss!
fruck it.
i dont even feel like going for tml's competition
firstly if frucking far and i cant find my red shrit.
%*&^$(*&)(&%&#(
we had better own tml's competition.
otherwise it'll totally be a wasted effort.
knn
guitar hero-ed at mikes hse again.
this time with the usual, adding abel and glendys
brought my laptop for nth luh
cause we didnt play L4D at all!
went for training
i swear, i've got to stop dropping discs
and constantly throwing properly!
sigh =(
oh wells.
at least i got friends to constantly remind me to be positive! =)
yay to that.haha
sat is the SFS competition
and sunday is winter league.
zzzZZZzz not sure if i can keep it up.
so much work and so much things to do!
=(
oh wells.
tml 1hour of tutorial
thats all -.-"
just 1hour in school
THAT 1HOUR.
freak it
i promise to cut down on my vulgarities. =)
cause its unglam. X)
oh yes.
i freaking hell need to be more aggressive in the game
but im scared =(
i freaking hell swear im damn scared alrdy.
cause i really duno where is my limit
(referring to my ankles)
and if i over push im afraid it'll give way AGAIN
ahhhh~
why do i evern have to fall into that nehneh pot hole
sigh.
learn and learn.
okay here is erm a song,
or rather u can jsut say lyrics
that i just came up for the pass 20mins
dont ask me to sing it for you
cause i totally cant.ahaha
oh wells
when insipration comes, theres no stopping
the world is ever-changing ,
theres nothing,that can be done to change it.
so i'll just make do with what i have now.
even though its so damn tough for me.
who is there to comfort me and
who is there to stand by me
tell me what am i suppose to do without any guide around
i cant believe time moves so fast
and im running and running
but im still, left, alone
im waiting, for that someone
to take me away
to somewhere new,to somewhere far
to somewhere we can live our life
without any pain
but somehow i cant see him
and i wonder if, i can make it through this life alone
had to skip inmolb lecture
because they bloody hell extended it to 2hours form 5-7pm
and im watching night at the museum 2 at 6.45 at the cathy
stupid lecturer,
she totally didnt tell us she'll move up the lecture last wk during our tutorial can
sigh.its like the second time i skip inmolb lecture for movie alrdy -.-"
wtblah!
anws
NIGHT AT THE MUSEUM 2 ROCKS!
its super super funny.
i totally dont mind watching it again
of cuz taking to account who im watching with luh
yay im happy =)
the movie made my day!
to side track abit
freaking hell!
i got my 1st B+ =(
nooooo =(
there goes my wish to get all As
freaking neh.disappointing
i did so much for that bloody report lei!
=(
oh wells.
oh yes
according to chris,
girls that swear hokkien vulgarities are unglam
LOL!
ok luh i do agree.
but thann..it doesnt mean i'll stop haha.
i'll just prolly cut down alittttle bit, just alittle.
im freaking tired now.
im totally not gona bother doing my practical report and phychem tutorial anymore.
fuck.im prepared to get D for all YAY!
shaltec.here i come?
December Babies
- Loyal and generous
- Patriotic
- Active in games and interactions
- Ambitious
- Influential in organisations
- Fun to be with
- Loves to socialise
- Loves praises
- Loves attention
- Loves to be loved
- Honest and trustworthy
- Not pretending
- Short tempered
- Changing personality
- Not egoistic
haha cool or what eh?haha
note the bolded words.ahaha
its exactly like me can.haha
anw ytd, went to np.
supposedly to watch a soccer match
but the opponent team didnt turn up at all.
seems like theres some miscommunication
but yea.oh wells
wasted trip down for me
but at least i brought my stuff to study =)
how smart am i! ahha
went to AMK after that
yes AMK.freaking far eh
ate dinner n played lan..
L4D baby! =)
im sorry
chris,mike,chua,iggy,jt,joakim,chris's brother
for having to see my ugly side =(
totally not a good impression..
cause i like dont wana waste my time at AMK
and end up going back home late and getting scolded for no reason
plus not like i dont have alot of work to do.so yea.
IM SORRY! =(
oh wells.
this kinda made me realise that im being more n more short-tempered
or maybe its in my blood LOL!
look at the list above!
or maybe i really just hate wastin time.
circle line,
can you be up ASAP!?!?!?!
why is it tat pasir pangjang mrt line takes forever to be done? =(
like NEXT YEAR!sigh.
im seriously considering to change school
to change to NP not shaltec!
ahhhh noo shaltec please =(
The Kill lyrics
Songwriters: Leto, Jared; What if I wanted to break
Laugh it all off in your face
What would you do?
What if I fell to the floor
Couldn't take all this anymore
What would you do, do, do?
Come break me down
Marry me, bury me
I am finished with you
What if I wanted to fight
Beg for the rest of my life
What would you do?
You say you wanted more
What are you waiting for?
I'm not running from you
Come break me down
Marry me, bury me
I am finished with you
Look in my eyes
You're killing me, killing me
All I wanted was you
I tried to be someone else
But nothing seemed to change
I know now, this is who I really am inside
Finally found myself
Fighting for a chance
I know now, this is who I really am
Come break me down
Marry me, bury me
I am finished with you, you, you
Look in my eyes
You're killing me, killing me
All I wanted was you
Come, break me down
Break me down
Break me down
What if I wanted to break?
What if I, what if I, what if I
Bury me, bury me
went to mike's hse aft school
guitar hero-ed and L4D
argh seriously
i hate staying so far from my friends
and i hate staying so far from school
i fucking hate my life.
seriously luh..
apart from the matter that they told me my relatives are coming to my hse last min
like tml at 2pm.
it is such a coincidence right
2pm when chris/mike/kenneth's soccer match starts
reallly fuck man.
why cant they come to my hse on sunday
or dont come at all
not like they can do anything at my hse
argh wdv k just fucking wdv
and oh yea
its so fucking easy to cope with my course -.-
like the phychem,math and so on
its like a piece of cake!totally!
fuck luh they just had to give me more pressure
by telling me
" you better work hard during this 3years.cause if you fail, you'll hv to go out and work.otherwise i'll just sent you to shaltec(i duno what school isit but yea) to learn to be a waitress. so you better study hard and cut down on frisbee.i dont even see you working hard at all. "
like yay rite.
i mean they ask me how i cope n stuff how the hell am i suppose to reply them?
not like even if i say i cant cope they can do anything
cause not like they know what im studying n they are gonna give me tuition
i have to depend on myself
to like ask my friends n to help me stuff
so whats the point of asking luh.seriously
they are like just giving me addition pressure
not like i dont get enough now.
i mean yea i totally admit im not trying hard enough
(trying hard means like taking every single wksheet n lesson seriously like a major exam is coming)
but i am trying
but you cant expect me to study n study rite
or like study infront of them
argh i duno luh.
i fucking hate it when ppl give me pressure
not like i dont give myself a huge amount of pressure
and how is tue,wed and sundays not cutting down on frisbee?
like seriously.
and like totally blame me for not being home everyday
when i hv school which is so fucking far from home.
FUCK luh.
someone just help me
it feels like im trapped in a room with no ways no escape
noone should tag on my board abt this post.
completely not in the mood to entertain
spare me your pity and sympathy
i swear i feel like dropping dead.
im soo darn tired.
anws went for lesson at 8.30 was late.as usual.
cant blame me. i stay super far plus i needed my slp X)
haha
went hang out with chris,kenneth,mike n mark
during my 3hour break
cause my class guys were playing soccer n i didnt wana sit in the sun so yea.
ermm lecture n tutorial was alright we ended early =) at 4pm YAY!
haha went to mike's hse for guitar hero n L4D
needed to release stress ahah
freaking hELLL!!
oh wells.
addicted to guitar hero drums n L4D now.
lalalala.
followed them to church -.-"
thanks to mike.
catholic church n christian church service are like totally different -.-"
well somewhat similar in a way but still! you know.
went for dinner after tat den came back home.
argh tired.
but im happy today
maybe because.....
1)erm..because i smoked again
2)some random guy said i was hot
(which i seriously dont think is the reason)
3)i played guitar hero n L4D today
oh wells.
i love dk =)


ALL THE BEST DK!
hope you guys play well for KL opens =)
have a safe trip people! =)
will miss you guys!
im super tired today
even though i didnt play much for frisbee
because i didnt hv my boots n ankle guards
thanks to my maid who washed it ytd -.-"
oh wells.
came home as early as i could aft training n aft dinner
in the end i still reached home abt 11 -.-"
fruck.
im freaking tired now.
ahhhhh~~
im stressed.super stressed
im like lagging behind in studies n frisbee
freaking hell..
once again, im stupid and useless.
i mean like seriously
for every qn tat i tried to do in the library before frisbee
i have to get michelle to teach me -.-
like for all 5qns with at most 3 parts.
5x3= 15questions!
haha im dumb.
i shld hv prolly gone to ite den to poly
it'll be soo much easier.
or stupid fmss shld hv just let me take triple science and amath -.-
den i wouldnt suffer like fruck now.
like seriously luh.
taking lit n art is a waste of time for me.
i dont even use it in my course!argh.
im pretty sure everyone in my class took amath
and im most likely the only one who doesnt.
ahhh~ freaking hellllll
sigh.
i cant keep up with the pace the lecturers and tutors are going
they just keep bombarding me with more n more stuff every lesson.
i dont hv time to study or revise
cause i end freaking late every day.
totally wtfruck man.
and i got noone to study with! =(
plus the notes isnt really helpful.AHHHHH
this is frucking worse den Olevels.
im not sure if i keep up this is amount of pressure
that im getting from both my studies n frisbee
and i dont know what do i take pride in anymore.
my studies is a gone case
so is frisbee..
so what is there to hold on to?
had presentation today.
freaking panic-ed when i went late for class because i had to change
and yea.
when i couldnt rmb what i wanted to say n when i scrabbled my sentence
and when i was accidentally being rude to phli
oh wells.
byebye presentation marks.
oh yea n i brought my laptop w/o charger.
well done right?ahaha
freaking
^*%^&$*^&(*%#$%^$
i realised i was slightly over-dressed when i changed back
from formal wear.
cause i had make-up on so i thought i'll be weird to wear shorts n shirt
with eyeliner,eye shadow,blusher n so on
plus i wanted to wear a comfortable top so yea..
-.-" seriously there isnt anything wrong wearing a classy top what.
oh wells.
i wore a top which overs 3/4 on my shorts
..well ok it almost cover my shorts
i didnt know it "grew" longer until i realise why was ppl staring at me.
cause i look like i wasnt wearing any shorts -.-
oh wells.
and freak i dont look like prostitute stupid you know who u are
wth luh.
so many other girls wear shirts covering almost their whole shorts also what
its just tat nyp girls hardly wear those type.
tsktsk.wdv!
anws, went to celebrate kaiyun's n xiulis birthday after our lesson
at amk mos burger
cause we have 4hour break..or rather they have 4 hour n i have 6hours
so yupp.hope they like the suprise =)
abt the cake n having it smashed on their face.ahaha
after tat we went to the library, did some work den they left
chris n kenneth was nice to accompany me in the library
den nat n his friend came.
went off to macs.
sat there, ate n talk bull
went of for lesson at 5pm
thanks nat for accompanying me to the LT
and chris for accompanying me half-way ahaha.
after lesson, went to meet chris n kenneth
den we went for lan
L4D baby! =)
well at least i managed to release some stress haha
you know you know
chris n myself realised we've got alot of common habits haha.
like...preferences and stuff.
you know haha.
so cool luh nv met anyone who wld almost hv exactly the same preference as me
lol.
freaking tired now.
i wana sleep but got test tml.
fruck.
oh wells.PHOTOS!
presentation tml baby.
sigh.
seriously im not prepared.
with the speech,outfit and make-up
totally wth.
went for dk training aft trying to study for phychem test
apparently i think even if i study or not,
it doesnt matter cause i dont understand a single thing.ahaha
im screwed tml.
played for summer league.
the sun is a killer.
we won.yay =)
get well soon connie! =)
im bloody tired.
6hours break tml.
WTF!haha
oh wells.screw it
i'm seriously trying very hard
even though i dont look like i am
and im losing it.
but i'll fucking fight for it..
it,
for my place in nyp ulti
i'll try my best to change his opinion about me..
and that im not hopeless
(even if it doesnt work, at least i tried)
for my freedom to play frisbee
and for my studies.
but for now,
i think i'll take a break.
one at a time, step by step.
cause its too much for me to handle.
i think im sick.
been having runs for more than a week now.
i think thats why i've been feeling weak and dizzy occasionally..
oh wells.
play for friends.
i dont know what to say
and
i dont know what to do.
never felt so entirely hopeless before.
i dont think im called a frisbee player anymore
since he gave up on me.
but i dont wana give up
whats so hilarious is that
when i thought i did try my best to improve,
it seems different to people.
i give them the impression that im slacking and i have to be spoon-fed
haha.
i dont know what to do anymore.
i dont wana give up.
they say im saying one thing but doing another thing.
haha.i seriously i seriously dont know whats wrong with me.
argh fuck.seriously, fuck.
i suck at my studies
and now i fucking suck at playing frisbee
i think have low IQ and EQ
haha fuck.
i'm pathetic.
and im fucking screwed tml.yay
2 phychem tutorials and 1organicchem tutorial not done yet.
tml there had better not be anyone irritating me
otherwise they'll get it from me.
which i hope i dont =/
i dont know what i exist anymore.
i'm stupid and practically useless.
yay -.-"
2012, had better be real.
so much work =(
done my report..
and maybe draft proposal(just copied the bloody sample)..
still got presentation for food culture and for cs
plus the tutorial worksheets.
someone kill me! =(
its no fair why my other friends hardly got any work at all
and why i got so much. =/
nonetheless,
i'll prove tat i can and will make it.
went for the pathetic 2hours of lessons
at 8.30am -.-"
was super tempted to pon it..
but if i really did,
i'll confirm pon the rest of it.. =/
lesson ended early,
so bh n i went to slack ard.
smoking is bad.dont try it.LOL
went to meet kaiyun at kranji
shopped at this fashion for formal wear.
kns so troublesome..
bought a office pants and top
den we had down to casueway point,
shopped for bh's tie lol.
den we went shopping for heels.
seriously,
one stupid lesson we got to buy so many stuff
esp when its stuff i wont wear at all..unless theres presentation -.-"
sians.esp the heels.omg can..
damn tired.
rushing through my lab report now.
you ever says poly is slacker than JC,
i'll so smack your face =x
i miss the times whereby i can do my work without any problems at all =(
so easy and less stressful
WEEE!
im finally back from KL
super tired =/
the trip back was horrible
cause the queue at the msia custom was damn damn long.
for those who can rmb..
its like all the way to the road. =/
oh wells.
tired..but not slpy
cause i slpt on the bus.
and yay tml is only 4hours of lesson
well..2hours cs 2hours prac =)
end at 1pm
but..i duno what to do after that =/
hello people =)
its my second day in KL.
im dead tired and i dont feel like doing my report/proposal/presentation/tutorial wksheets =(
oh wells.
i'll be back tml evening! =)
anyone kind enough to lend me a helping hand...
or rather part of his/her smartness to help me with my work? =/
Day 1
okay this isnt exactly day one..but yea.
took a bus to KL.
the bus ride was soooo long.
reached KL like 1am++
so yea.slpt quite late.
woke up.
went to shop around mid valley.
didnt buy much cause most of the stuff in mid valley is quite expensive
its funny that the branded goods in KL are more expensive compared to the ones in singapore.
hmm..i think by the end of this trip,
i would have built up my stamina haha X)
been walking for 4 or 5 hours straight luh!
retarded.haha..
they got this super huge pet shop.
i love it! =)
you know what, maybe next time i'll either be a vet..or i'll own a cat shop+veterinary service+cat hotel.
awesome or what!
haha..i can keep dreaming, till it happens.LOL!
we went for a midnight movie later that evening.
watched wolverine in a gold class theatre.
awesome ot what! =)
its like super super spacious, you can like lie back den the chair will adjust
like a sofa!we can rent blankets too! =)
superr nice =) i love it!
movie ended at 1am+ den went back to sleep.
Day2
woke up at 8am,
had breakfast den took public transport to bukit bintang..
shopping paradise X) that is if u have money.haha
but the stuff there are quite cheap also luh..
bought alot of clothes! =)
looks like i'll nv get bored of clothes..anymore..
well, at least for the next 6months.
the only stuff i cant find
is shoes..or rather, footwear.
so pissting..theres like sooo many footwear shop n i cant find what i like =(
okay, i bought a pair of heels n flip-flops.but i need a cover-ed toe one
for the stupid practical =/
i cant find any nice one..most are either too formal
or cheena. =x
looks like i'll hv to get them in singapore..
after lunch, we went for a spa treatment..
you know the fishys..
i think the fishes are super cute! =)
most of the are mostly brown with a pink mouth.LOL
cute or what!ahaha
but they are quite fierce =/
as in they'll attack your feet.haha
i make it sound its a horrible treatment..
well it is for those who are afraid of tickles..ppl like me =/
in the beginning i felt like jumping out of the water
but after awhile i got used to it.
my skin was smooth after the fishys had their meal =)
went for dinner at times square
the duck was super good! =) better den singapore's plus its cheap.hehe
so yea..
my dad wanted to try the executive class for the hotel so we had to check in the hotel again before 7pm
honestly, there isnt any difference between the normal and the executive class..
now we have additional stuff in the room..like a long mirror n a weighing machine..
its SO executive man! -.-"
i thought that the room will be bigger n have a bigger toilet
(i have a thing for nice toilets,dont ask me why)
but we do have the privilege of slacking at the executive lounge.
the food, is awesome =)
so yea..
today is a very very tiring day..
been walking non-stop.lol
and
i think...i think
i'm a shopaholic =(
i spend money like no ones business
i feel guilty, but happy when i bought the stuff.
i just hope, i'll use them back in singapore..
esp the Levis jeans =/
shall upload some of the photos when im free
back to work =(